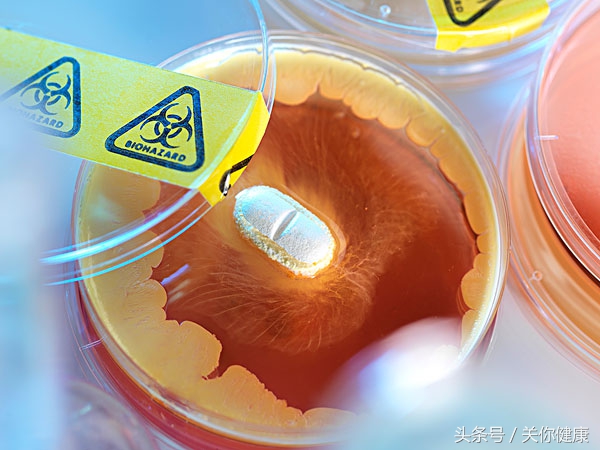
抗生素耐药的病人该怎么办,抗生素耐药寻找安全之路

2017年11月13日到19日,是世界提高抗生素认识周,活动的主题是,服用抗生素前要咨询合格医务人员。《关你医事》带您去了解一下相关的背景。咱们先做个测试,来,准备好纸和笔,开始。

这组测试题,是由世界卫生组织提供的,先做一下再对照答案和解释,看看您对抗生素耐药性了解了多少。
题1,抗生素是帮助抗击以下哪一项的强大药物:A病毒;B细菌;C所有微生物;
题2,身体在抵御抗生素时,就会发生抗生素耐药性:A对;B错;
题3,抗生素耐药细菌会通过以下哪一项在人类间传播:A与有抗生素耐性感染的人接触;B与抗生素耐药感染的人接触过的事件,比如工作人员的手或卫生较差的环境内的器具等;C接触携带抗生素耐药细菌的动物、食物或水;D以上全是;
题4,如果发生抗生素耐药感染后会怎么样?A生病的时间可能更长;B可能需要更多次看医生或接受治疗;C需要更贵并可能产生副作用的药物;D以上全是;
题5,抗生素耐药性已经失控并只会逐渐恶化,而我却什么也做不了:A对;B错;
题6,以下哪些事可帮助应对抗生素耐药:A向生病的家人提供我使用的抗生素;B感觉生病就到药房买或到别人那儿拿抗生素来服用;C及时接种所需疫苗。
答完了题,先稍放松下,我们先去了解相关的背景,再对答案。

世界卫生组织之所以连续几年发起提高抗生素认识周活动,是因为抗生素耐药性已经成为全球卫生、食品安全和发展的最大威胁之一。抗生素耐药性会影响到每一个人,越来越多的感染,比如肺炎、结核病、淋病等,变得更难治疗,这直接导致了住院时间延长、医疗费用增加和死亡率的上升。

抗生素是用于预防和治疗细菌感染的药物,耐药性是在药物使用过程中,所引起的细菌对药物反应的改变,这些产生耐药的细菌有时被称为“超级细菌”,会感染人类或动物。药物失去效果,感染持续不断,加剧传染他人的风险,感染得不到有效控制时会带来死亡。

抗生素耐药性通常认为是随着基因变化而发生的一种自然现象,但误用或滥用抗生素会加快形成耐药性,由于抗生素使用缺乏专业监督,有人使用抗生素治疗感冒等病毒性感染,或将抗生素用于动物养殖或鱼类生长的促进剂。微生物具有耐药性后,会通过动物接触、处理不当的食物、卫生条件较差的环境等传播。
受到耐药菌株感染的患者所面临的是更多医疗资源和死亡风险。我们来看几个典型:克雷伯菌是肺炎、出血感染、新生儿和重症监护患者感染的祸根,以往可用碳青霉烯类抗生素有效控制,但由于耐药出现,现在半数以上对碳青霉烯类治疗无效;氟喹诺酮类曾广泛用于治疗大肠杆菌引起的尿路感染,现在耐药也在半数以上;至少10个国家报道,第三代头孢对淋病治疗失败,最后的药物手段也没用了;耐甲氧西林金黄色葡萄球菌感染比非耐药的死亡率高出64%。

粘菌素是治疗碳青霉烯类耐药肠杆菌感染的最后杀器,最近也出现耐药。结核病这类已经快被完全控制消灭的疾病,新发病例超过3%是耐药的,曾接受过治疗的患者中,耐药比例已超20%,现在约10%的病例是对至少4种核心抗结核病药耐药的,在至少105个国家和地区都出现了广泛耐药结核病。

正如世界卫生组织所指,抗生素是一种珍贵资源,负责任地使用抗生素才能确保得到最佳治疗,这就需要公众也参与形成正确的认识。这件事,没有人可以当吃瓜群众。普通百姓要记住关键信息:抗生素是治疗细菌感染的,不能治愈感冒或流感等病毒引起的感染,如在不必要时滥用抗生素,在真正需要时就可能失去作用;抗生素针对的是细菌,产生耐药的也是细菌,如果受到耐药菌感染,以前对付这种菌的抗生素就不再有效,那就不得不用昂贵的最后手段的抗生素,有时会最终无药可选;耐药细菌会通过接触传染,要常洗手,咳嗽打喷嚏时请捂嘴鼻不要对着别人;耐药感染更严重可能需入院治疗;对付耐药性需大家努力,需服用抗生素时要向专业人员咨询,不要自行使用也不要与人分享。

好啦,现在我们来看下小测试的正确答案:1B;2B;3D;4D;5B;6C.您答对了多少?带给家人和朋友也一起测一测吧。
爱谁,就把健康传给谁。
你的健康,我的关注。专业人员制作,以科学与人文视角多维度观察生命健康,包括医事、史话、日常、展望、心理、房内等系列,内容为作者魏宏岭及团队原创作品。拒绝未经许可的一切形式的盗用、盗链及转载,否则将依据相关法律予以追究。